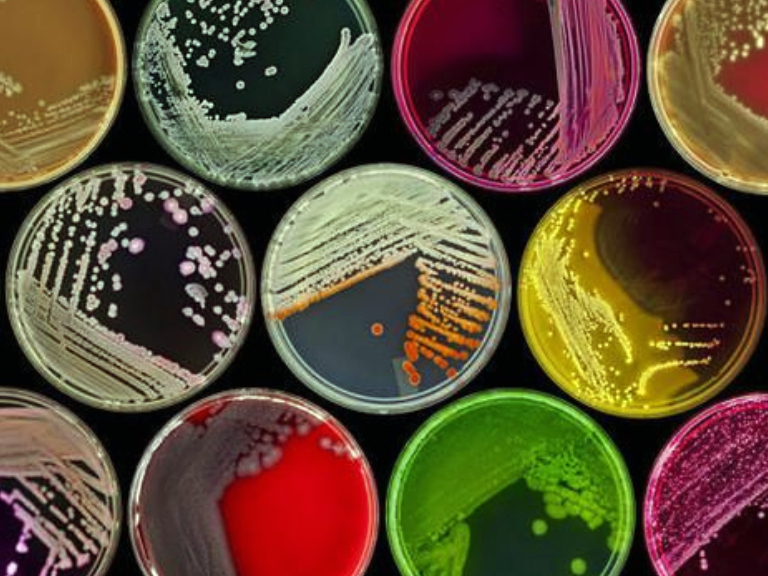

Sífilis y su ruta bacteriológica
Mientras algunos científicos sostienen que Treponema pallidum llegó desde América a Europa tras los viajes de Colón, nueva información indica que esta ya existía en el Viejo Continente a fines del siglo XV.
Un 12 de octubre de 1492, Cristóbal Colón llegó al Nuevo Mundo, después de una expedición de dos meses y nueve días y que pudo llevar a cabo con el apoyo de los reyes de España, Isabel y Fernando de Castilla y Aragón.
El navegante genovés pretendía encontrar una nueva ruta a la India como habían hecho años antes los portugueses. En ese intento descubrió accidentalmente para la civilización occidental tierras de las que no se tenía conocimiento y que proporcionaron grandes fortunas y también dolores de cabeza.
Uno de ellos habría sido que al regreso de la histórica navegación, además de frutas, hortalizas, tabaco, especias y esclavos, el explorador llevó a bordo de la Pinta o la Santa María un polizón: la cepa de la bacteria Treponema pallidum pallidum (TPA), causante de la sífilis, teoría que, por muchos años, se consideró factible.
Esta es una de las infecciones de transmisión sexual que, superada solamente por el VIH/SIDA, ha tenido efectos devastadores y aún constituye un problema de salud. Se trata de una enfermedad reemergente, que ha marcado la historia europea con una devastadora epidemia a finales del siglo XV, la que causó estragos hasta el siglo XVIII, por sus elevadas tasas de mortalidad.
Junto con las patologías treponémicas no venéreas -como el bejel y pian, que se encuentran en las regiones tropicales y subtropicales- representa una amenaza para la salud. Según la OMS, anualmente, se registran más de 6,3 millones de casos.
Durante mucho tiempo, la expedición fue considerada culpable de llevar con ella la nueva enfermedad, porque esta se extendió durante la guerra de Nápoles por todo el Viejo Continente en 1495, dos años después del regreso, por separado, de las dos naves supervivientes, causando una severa epidemia que, por entonces, era letal y se trataba inhalando nocivos vapores de mercurio.
Sin embargo, investigadores del Instituto de Medicina Evolutiva de la Universidad de Zúrich en Suiza intentan resolver esta controversia. En un reciente estudio publicado en la revista Current Biology dieron a conocer que la sífilis realmente existía en Europa mucho antes de que Colón zarpara hacia América [1].
La literatura medieval menciona casos de sífilis, pero a menudo “su diagnóstico se confunde con otras enfermedades y se la denomina falsamente lepra ‘venérea’ o ‘hereditaria’. Si bien se han reportado restos humanos precolombinos con marcas características de TPA, estos no están confirmados con evidencia genética. Pero ahora lo detectamos en restos humanos hallados en Finlandia, Estonia y los Países Bajos, datados entre comienzos del siglo XV y el XVIII.”, explica la doctora Verena Schünemann, directora del estudio y miembro del Instituto de Medicina Evolutiva de la Universidad de Zúrich.
La hipótesis alternativa multirregional supone la presencia precolombina de TPA en el continente europeo, potencialmente como resultado de la propagación prehistórica de la enfermedad a través de rutas africanas y asiáticas [2].
Para demostrar aquello, con la secuenciación de genomas y pruebas de radiocarbono, los investigadores suizos demostraron que una variedad de cepas relacionadas tanto con la sífilis venérea como con la subespecie que causa el pian, ya estaban presentes en el norte del continente europeo en el período moderno temprano.
También descubrieron un patógeno que pertenecía a un linaje treponémico nuevo, desconocido y basal, recuperado como grupo hermano de los que causan pian y bejel, pero que ya no está presente. “Esto es particularmente emocionante para nosotros, porque es genéticamente similar a todas las subespecies treponémicas actuales, pero tiene cualidades únicas que difieren de ellas”.
Los análisis genéticos sugieren que el predecesor de todas las subespecies modernas de TPA probablemente evolucionó hace al menos 2.500 años y que para la sífilis, el último ancestro común existió entre los siglos XII y XVI, lo que podría significar que la diversidad de treponematosis durante ese tiempo pudo haberse desarrollado en el continente europeo incluso antes de los contactos intercontinentales.
Los autores, eso sí, destacan que “quizás se produjeron recombinaciones entre las cepas importadas de América y las endémicas de Europa, precipitando la epidemia en el último continente. Por lo que el primer brote conocido no puede atribuirse únicamente a los viajes de Colón. Es posible que estas nuevas aproximaciones nos lleven a revisar nuestras teorías sobre los orígenes de la sífilis y otras enfermedades treponémicas”.
Cristóbal Colón padeció varias patologías en sus cuatro desplazamientos a América: blefaritis, diarreas disentéricas, escorbuto, gripe, fiebre palúdica e inespecíficas, enfermedad de Reiter, paludismo, gota y sífilis. Según la bitácora médica, esta última la contrajo en su tercer periplo.
La diversidad de enfermedades causadas por bacterias treponémicas y la composición de su árbol genealógico sugieren un origen europeo de la sífilis. Con las actuales pruebas se podría exculpar al navegante de diseminar la Treponema pallidum en el Viejo Mundo hace 528 años y, al mismo tiempo, mejorar el conocimiento actual para establecer medidas más eficaces sobre su vigilancia y control.
[1] Majander K, Pfrengle S, Kocher A, et al. Ancient Bacterial Genomes Reveal a High Diversity of Treponema pallidum Strains in Early Modern Europe. Curr Biol. 2020;S0960-9822(20)31083-6.
[2] Meyer C, Jung C, Kohl T, Poenicke A, Poppe A, Alt KW. Syphilis 2001--a palaeopathological reappraisal. Homo. 2002;53(1):39-58.
Por Carolina Faraldo Portus
Temas Relacionados